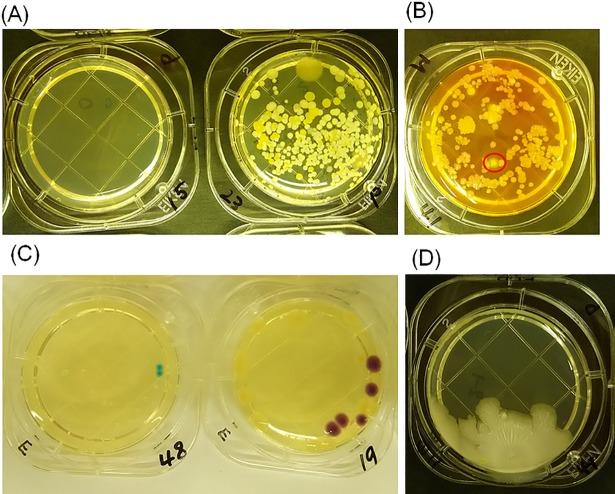
https://cdn.ncbi.nlm.nih.gov/pmc/blobs/ce30/6169843/76ff8e9caf94/pone.0198300.g001.jpg

纳米压印蛾眼薄膜在实际环境中的抗菌效果。
Antibacterial effects of nano-imprinted moth-eye film in practical settings.
机构信息
Display Technology Development Center, Development Group, Display Device Company, Sharp Corporation, Tenri, Nara, Japan.
New Business Promotion Center, Development Group, Display Device Company, Sharp Corporation, Tenri, Nara, Japan.
出版信息
PLoS One. 2018 Oct 3;13(10):e0198300. doi: 10.1371/journal.pone.0198300. eCollection 2018.
BACKGROUND
Recent studies report that surfaces displaying micrometer- or nanometer-sized undulating structures exhibit antibacterial effects. In previous work, we described the use of an advanced nanofabrication technique to generate an artificial biomimetic Moth-eye film by coating a polyethylene terephthalate (PET) film with nanoscale moth-eye protrusions made from a hydrophilic resin. This moth-eye film exhibited enhanced antibacterial effects in in vitro experiments. The aim of the present study was to verify the antibacterial efficacy of the Moth-eye film in practical environments.
MATERIALS AND METHODS
The antibacterial effects of three types of film (Moth-eye film, Flat film, and PET film) were compared. Sample films were pasted onto hand washing basins at the testing locations. After several hours, bacteria were collected from the surface of the sample films with one of three kinds of culture media stamper (to permit identification of bacterial species). The stampers were incubated for 48 hours at 35°C, and the numbers of colonies were counted.
RESULTS AND DISCUSSION
The number of common bacteria including E. coli and S. aureus obtained from the Moth-eye film was significantly lower than those from the PET film (p<0.05) and Flat film at 1 hour (p<0.05). This study found that the Moth-eye film showed a long-term (6h) antibacterial effect and the Moth-eye structure (PET coated with nanoscale cone-shaped pillars) demonstrated a physical antibacterial effect from earlier time points. Therefore, the Moth-eye film appears to have potential general-purpose applications in practical environments.
背景
最近的研究报告表明,显示微米或纳米级凹凸结构的表面具有抗菌效果。在之前的工作中,我们描述了使用先进的纳米制造技术通过在聚对苯二甲酸乙二醇酯(PET)膜上涂覆由亲水性树脂制成的纳米级蛾眼突起来生成人工仿生蛾眼膜。该蛾眼膜在体外实验中表现出增强的抗菌效果。本研究旨在验证蛾眼膜在实际环境中的抗菌功效。
材料与方法
比较了三种类型的膜(蛾眼膜、平膜和 PET 膜)的抗菌效果。将样品膜粘贴在测试位置的洗手盆上。几个小时后,用三种培养基于不同的方法从样品膜表面收集细菌(以鉴定细菌种类)。将印模在 35°C 下孵育 48 小时,然后计数菌落数。
结果与讨论
从蛾眼膜中获得的包括大肠杆菌和金黄色葡萄球菌在内的常见细菌数量明显低于 PET 膜(p<0.05)和平膜在 1 小时时(p<0.05)的数量。本研究发现,蛾眼膜具有长期(6 小时)的抗菌效果,蛾眼结构(涂覆有纳米锥形柱的 PET)从早期就表现出物理抗菌效果。因此,蛾眼膜似乎在实际环境中具有潜在的通用应用前景。